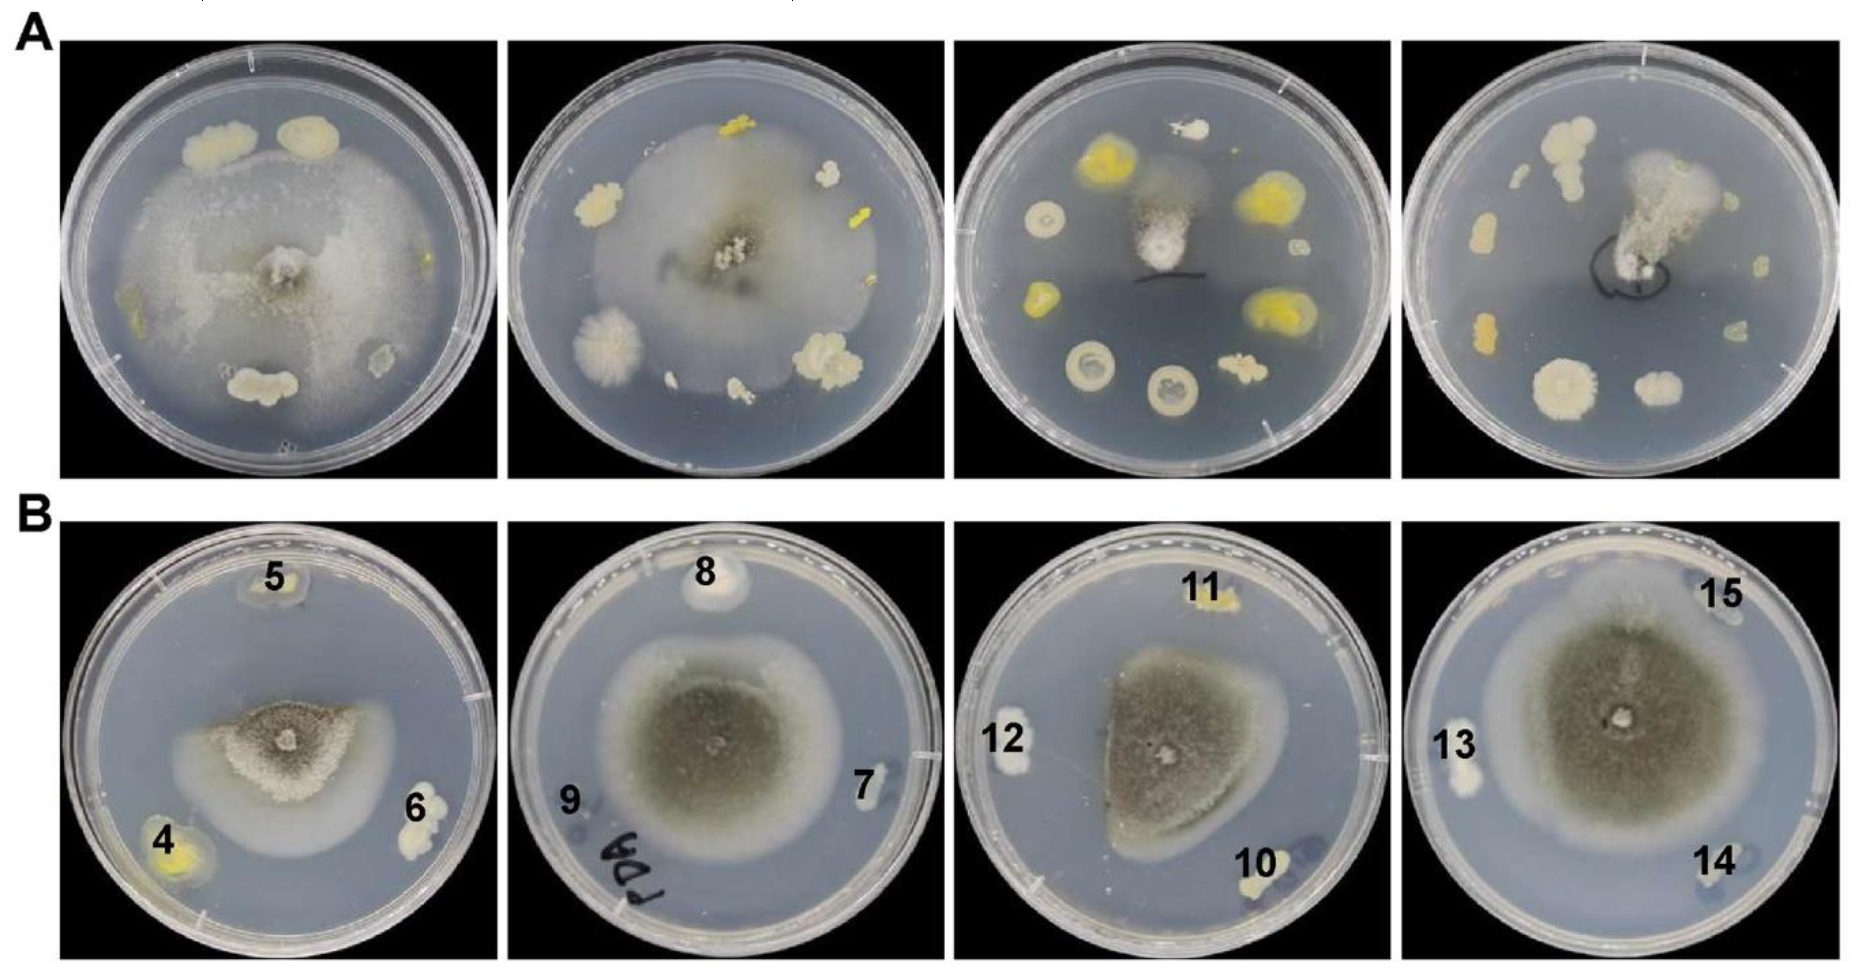
Ijerph 17 05248 g001

Suppression of Rice Blast by Bacterial Strains Isolated from Cultivated Soda Saline-Sodic Soils
Abstract
1. Introduction
2. Materials and Methods
2.1. Fungal Strains and Culture Conditions
2.2. Soil Sample Collection
2.3. Isolation of Bacteria from Soil Samples
2.4. Screening of Antagonistic Strains against M. oryzae
2.5. Identification of Bacterial Strains by 16S rRNA Analysis
2.6. Conidial Germination Assay
2.7. Pathogenicity Suppression Assays
3. Results
3.1. Isolation and Screening of Antagonistic Bacterial Strains against M. oryzae from Soda Saline-Sodic Rice Fields
3.2. Molecular Identification of the Isolated Antagonistic Bacterial Strains
3.3. Inhibitions of Mycelial Growth of M. Oryzae by the Isolated Antagonistic Bacterial Strains
3.4. Bacterial Strains JLS5 and JLS12 Inhibit Conidial Germination of M. Oryzae
3.5. Suppressions of M. Oryzae Pathogenicity on Host Leaves by the Isolated Antagonistic Bacterial Strains JLS5 and JLS12
3.6. Control of Rice Blast Disease on Rice Seedlings by the Isolated Antagonistic Bacterial Strains JLS5 and JLS12 in Greenhouse
4. Discussion
5. Conclusions
Author Contributions
Funding
Acknowledgments
Conflicts of Interest
References
- Howard, R.J.; Valent, B. Breaking and entering: Host penetration by the fungal rice blast pathogen Magnaporthe grisea. Annu. Rev. Microbiol. 1996, 50, 491–512. [Google Scholar] [CrossRef] [PubMed]
- Talbot, N.J. On the trail of a cereal killer: Exploring the biology of Magnaporthe grisea. Annu. Rev. Microbiol. 2003, 57, 177–202. [Google Scholar] [CrossRef] [PubMed]
- Deng, Y.Z.; Naqvi, N.I. Metabolic Basis of Pathogenesis and Host Adaptation in Rice Blast. Annu. Rev. Microbiol. 2019, 73, 601–619. [Google Scholar] [CrossRef] [PubMed]
- Leneveu-Jenvrin, C.; Charles, F.; Barba, F.J.; Remize, F. Role of biological control agents and physical treatments in maintaining the quality of fresh and minimally-processed fruit and vegetables. Crit. Rev. Food Sci. Nutr. 2019, 60, 1–19. [Google Scholar] [CrossRef] [PubMed]
- Moraes Bazioli, J.; Belinato, J.R.; Costa, J.H.; Akiyama, D.Y.; Pontes, J.G.M.; Kupper, K.C.; Augusto, F.; de Carvalho, J.E.; Fill, T.P. Biological Control of Citrus Postharvest Phytopathogens. Toxins 2019, 11, 460. [Google Scholar] [CrossRef] [PubMed]
- Kohl, J.; Kolnaar, R.; Ravensberg, W.J. Mode of Action of Microbial Biological Control Agents Against Plant Diseases: Relevance Beyond Efficacy. Front. Plant. Sci. 2019, 10, 845. [Google Scholar] [CrossRef]
- Li, H.; Guan, Y.; Dong, Y.; Zhao, L.; Rong, S.; Chen, W.; Lv, M.; Xu, H.; Gao, X.; Chen, R.; et al. Isolation and evaluation of endophytic Bacillus tequilensis GYLH001 with potential application for biological control of Magnaporthe oryzae. PLoS ONE 2018, 13, e0203505. [Google Scholar] [CrossRef]
- Rong, S.; Xu, H.; Li, L.; Chen, R.; Gao, X.; Xu, Z. Antifungal activity of endophytic Bacillus safensis B21 and its potential application as a biopesticide to control rice blast. Pestic Biochem. Physiol. 2020, 162, 69–77. [Google Scholar] [CrossRef]
- Filippi, M.C.C.; da Silva, G.B.; Silva-Lobo, V.L.; Côrtes, M.V.C.B.; Moraes, A.J.G.; Prabhu, A.S. Leaf blast (Magnaporthe oryzae) suppression and growth promotion by rhizobacteria on aerobic rice in Brazil. Biol. Control. 2011, 58, 160–166. [Google Scholar] [CrossRef]
- Huang, W.; Liu, X.; Zhou, X.; Wang, X.; Liu, X.; Liu, H. Calcium Signaling Is Suppressed in Magnaporthe oryzae Conidia by Bacillus cereus HS24. Phytopathology 2020, 110, 309–316. [Google Scholar] [CrossRef]
- Tokpah, D.P.; Li, H.; Wang, L.; Liu, X.; Mulbah, Q.S.; Liu, H. An assessment system for screening effective bacteria as biological control agents against Magnaporthe grisea on rice. Biol. Control. 2016, 103, 21–29. [Google Scholar] [CrossRef]
- Chaiharn, M.; Theantana, T.; Pathom-Aree, W. Evaluation of Biocontrol Activities of Streptomyces spp. against Rice Blast Disease Fungi. Pathogens 2020, 9, 126. [Google Scholar] [CrossRef]
- Yu, W.Q.; Zheng, G.P.; Qiu, W.; Yan, F.C.; Liu, W.Z.; Liu, W.X. Draft genome sequence, disease-resistance genes, and phenotype of a Paenibacillus terrae strain (NK3-4) with the potential to control plant diseases. Genome 2018, 61, 725–734. [Google Scholar] [CrossRef] [PubMed]
- Yu, Q.; Liu, Z.; Lin, D.; Zhang, W.; Sun, Q.; Zhu, J.; Lin, M. Characterization and evaluation of Staphylococcus sp. strain LZ16 for the biological control of rice blast caused by Magnaporthe oryzae. Biol. Control. 2013, 65, 338–347. [Google Scholar] [CrossRef]
- Li, Q.; Jiang, Y.; Ning, P.; Zheng, L.; Huang, J.; Li, G.; Jiang, D.; Hsiang, T. Suppression of Magnaporthe oryzae by culture filtrates of Streptomyces globisporus JK-1. Biol. Control. 2011, 58, 139–148. [Google Scholar] [CrossRef]
- Zheng, F.; Yang, Q.; Zhao, Z.; Li, J. Variability of pathogenicity of Pyricularia oryzae. J. Yunnan Agric. Univ. 1998, 13, 20–24. [Google Scholar]
- Li, G.; Zhou, Z.; Liu, G.; Zheng, F.; He, C. Characterization of T-DNA insertion patterns in the genome of rice blast fungus Magnaporthe oryzae. Curr. Genet. 2007, 51, 233–243. [Google Scholar] [CrossRef]
- Cui, X.; Wei, Y.; Wang, Y.H.; Li, J.; Wong, F.L.; Zheng, Y.J.; Yan, H.; Liu, S.S.; Liu, J.L.; Jia, B.L.; et al. Proteins interacting with mitochondrial ATP-dependent Lon protease (MAP1) in Magnaporthe oryzae are involved in rice blast disease. Mol. Plant. Pathol. 2015, 16, 847–859. [Google Scholar] [CrossRef]
- Wilson, K. Preparation of genomic DNA from bacteria. Curr. Protoc. Mol. Biol. 2001, 56, 2–4. [Google Scholar] [CrossRef]
- Kumar, S.; Stecher, G.; Li, M.; Knyaz, C.; Tamura, K. MEGA X: Molecular Evolutionary Genetics Analysis across Computing Platforms. Mol. Biol. Evol. 2018, 35, 1547–1549. [Google Scholar] [CrossRef]
- Koga, H.; Dohi, K.; Nakayachi, O.; Mori, M. A novel inoculation method of Magnaporthe grisea for cytological observation of the infection process using intact leaf sheaths of rice plants. Physiol. Mol. Plant. Pathol. 2004, 64, 67–72. [Google Scholar] [CrossRef]
- Long, B.; Li, G.-H.; Feng, R.-R.; Tao, L.; Liu, D.-D.; Feng, H.-Q.; Qin, Q.-M. NTPDase Specific Inhibitors Suppress Rice Infection by Magnaporthe oryzae. J. Phytopathol. 2015, 163, 227–232. [Google Scholar] [CrossRef]
- Stille, L.; Smeets, E.; Wicke, B.; Singh, R.; Singh, G. The economic performance of four (agro-) forestry systems on alkaline soils in the state of Haryana in India. Energy Sustain. Dev. 2011, 15, 388–397. [Google Scholar] [CrossRef]
- Yang, F.; An, F.; Ma, H.; Wang, Z.; Zhou, X.; Liu, Z. Variations on Soil Salinity and Sodicity and Its Driving Factors Analysis under Microtopography in Different Hydrological Conditions. Water 2016, 8, 227. [Google Scholar] [CrossRef]

| Soil Sample | pH | Collection Location | Altitude (m) | Numbers of Bacteria | ||
|---|---|---|---|---|---|---|
| North Latitude | East Longitude | Total | Antagonistic 1 | |||
| #1 | 8.03 | 45°01′06″ | 124°36′10″ | 130 | 16 | 2 |
| #2 | 8.08 | 45°01′06″ | 124°36′10″ | 130 | 11 | 0 |
| #3 | 7.94 | 45°01′06″ | 124°36′10″ | 130 | 11 | 1 |
| #4 | 8.51 | 44°57′19″ | 124°38′14″ | 140 | 11 | 0 |
| #5 | 8.11 | 44°59′40″ | 124°40′54″ | 130 | 11 | 0 |
| #6 | 8.00 | 44°59′40″ | 124°42′47″ | 140 | 11 | 2 |
| #7 | 8.19 | 45°00′00″ | 124°42′27″ | 130 | 11 | 4 |
| Strain | Inhibition Effect on M. oryzae Growth 1 | Identification | Soil Sample |
|---|---|---|---|
| JLS5 | +++++++ | Bacillus safensis | #6 |
| JLS8 | + | Pseudomonas koreensis | #7 |
| JLS10 | +++ | Pseudomonas saponiphila | #7 |
| JLS11 | +++++ | Stenotrophomonas rhizophila | #7 |
| JLS12 | +++++++ | Bacillus tequilensis | #7 |
© 2020 by the authors. Licensee MDPI, Basel, Switzerland. This article is an open access article distributed under the terms and conditions of the Creative Commons Attribution (CC BY) license (http://creativecommons.org/licenses/by/4.0/).
Share and Cite
Wei, Y.; Li, L.; Hu, W.; Ju, H.; Zhang, M.; Qin, Q.; Zhang, S.; Li, G. Suppression of Rice Blast by Bacterial Strains Isolated from Cultivated Soda Saline-Sodic Soils. Int. J. Environ. Res. Public Health 2020, 17, 5248. https://doi.org/10.3390/ijerph17145248
Wei Y, Li L, Hu W, Ju H, Zhang M, Qin Q, Zhang S, Li G. Suppression of Rice Blast by Bacterial Strains Isolated from Cultivated Soda Saline-Sodic Soils. International Journal of Environmental Research and Public Health. 2020; 17(14):5248. https://doi.org/10.3390/ijerph17145248
Chicago/Turabian StyleWei, Yi, Lanhui Li, Wenjun Hu, Huiyan Ju, Mingzhe Zhang, Qingming Qin, Shihong Zhang, and Guihua Li. 2020. "Suppression of Rice Blast by Bacterial Strains Isolated from Cultivated Soda Saline-Sodic Soils" International Journal of Environmental Research and Public Health 17, no. 14: 5248. https://doi.org/10.3390/ijerph17145248
APA StyleWei, Y., Li, L., Hu, W., Ju, H., Zhang, M., Qin, Q., Zhang, S., & Li, G. (2020). Suppression of Rice Blast by Bacterial Strains Isolated from Cultivated Soda Saline-Sodic Soils. International Journal of Environmental Research and Public Health, 17(14), 5248. https://doi.org/10.3390/ijerph17145248

